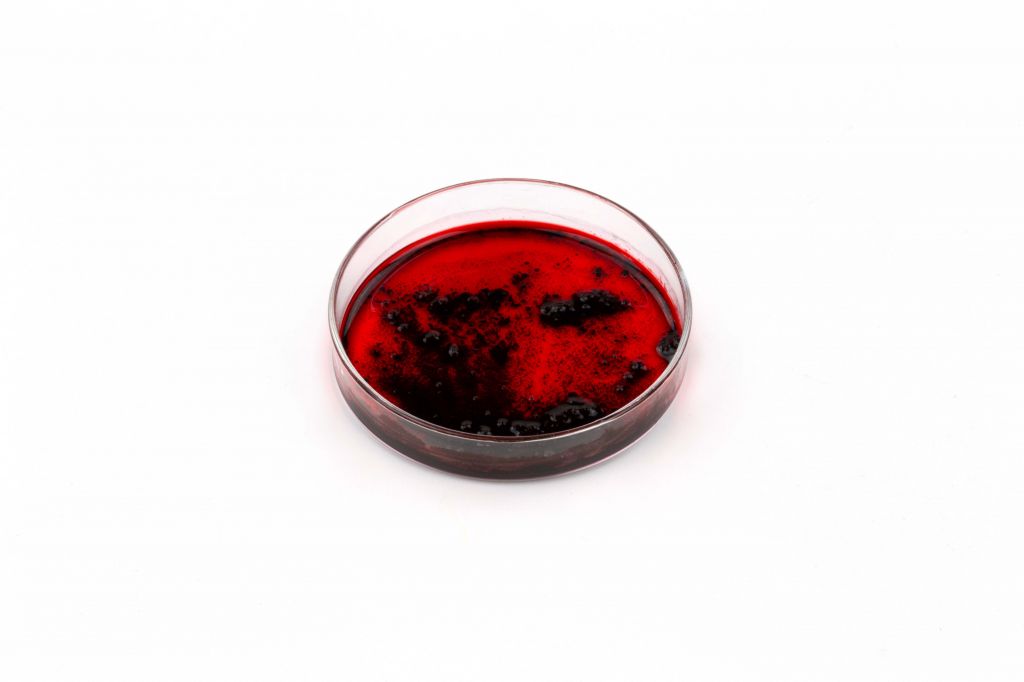
Vosková červená O, Solvent Red 27, 1 kg

Vosková červená O, Solvent Red 27, 1 kg

VÝHRADNÍ ZASTOUPENÍJsme přímí dovozci a oficiální prodejci světových značek CTS, Kremer, Lascaux a dalších
ODBORNÉ PORADENSTVÍPomůžeme vám s výběrem správných materiálů i postupů.
VĚRNOSTNÍ PROGRAMZaložte si účet a nakupujte levněji díky našim slevám.
ZASÍLÁME DO ZAHRANIČÍSpolehlivě doručujeme po celé Evropě s možností pohodlné platby v EUR.- Kompletní specifikace
- Hodnocení 0
- Komentáře 0
- Ke stažení
Vosková červená O, Solvent Red 27, 1 kg6 - 12 pracovních dnů9 699,36 Kč/ ks8 016,00 Kč bez DPH
Vosková červená O (Solvent Red 27)
Další názvy: Oil Red O, Sudan Red 5B, Wax Red, Fettrot, C.I. 26125 je lyzochromní (v tucích rozpustné) diazobarvivo používané k barvení vosků, olejů a tuků.
Tato barviva se rozpouštějí v roztaveném vosku, oleji nebo Shellsol T.
Technická data:
Chemické složení: Solvent Red 27, C.I. 26 125
ColorIndex: SR 27.26125
Vhodnost: barvení
Barva: červená
Forma: prášek
Rozpustnost ve vodě: nerozpustný